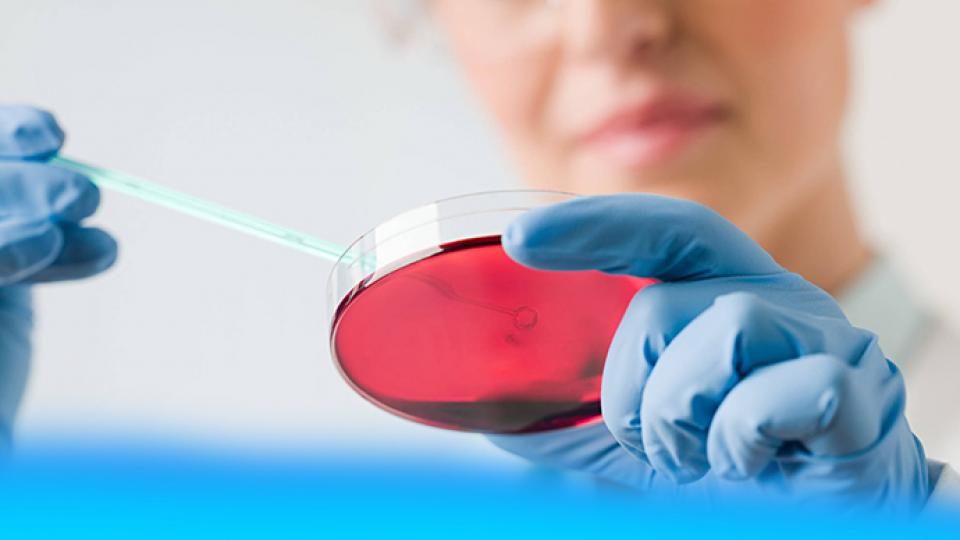

Купить Климонорм в Арске

👉🏻👉🏻👉🏻 ВСЯ ИНФОРМАЦИЯ ДОСТУПНА ЗДЕСЬ, ЖМИТЕ 👈🏻👈🏻👈🏻
КЛИМОНОРМ цена и наличие в аптеках, где купить Климонорм в . . .
Климонорм - купить, цена, доставка и отзывы, Климонорм . . .
Климонорм - инструкция по применению, цена на Климонорм и . . .
Климонорм - купить по низкой цене в интернет‐аптеке, заказать
Климонорм таблетки покрытые оболочкой, 21 шт .: инструкция . . .
Климонорм инструкция по применению, цена в аптеках Украины . . .
Климонорм® (Klimonorm®), инструкция, способ применения и . . .
Климонорм комби-упак .: таб ., п/о №21 в упак . : инструкция . . .
КЛИМОНОРМ цены и наличие в аптеках Киева . Купить по . . .
Климонорм цена в аптеках Москвы, купить - Поиск лекарств
Сколько Нужно Амброксола Для Ингаляций Взрослым
Купить Фиточистин в Альметьевске
Купить Реддитукс в Альметьевске
Где купить Климонорм - цены, адреса и телефоны аптек, информация о наличии и сравнение цен на Климонорм в аптеках Украины
Благодаря составу и циклической схеме приема Климонорм, (приём только эстрогена в течение 9 дней, затем - комбинации эстрогена и гестагена в течение 12 дней, и, наконец, 7-дневный перерыв), у . . .
Благодаря составу и циклической схеме приема Климонорм (прием только эстрогена в течение 9 дней, затем - комбинации эстрогена и гестагена в течение 12 дней и затем - 7-дневный перерыв), у . . .
Купить Климонорм в интернет-аптеке в Москве по низкой цене . Подобрать более дешевые заменители и аналоги Климонорм . Официальная инструкция по применению .
Климонорм таблетки покрытые оболочкой, 21 шт . купить по низкой цене в Киеве, Харькове, Одессе и в Украине Доставка лекарств домой ️ Наличие в аптеках Украины . 🧐 Вы сможете забрать Климонорм таблетки покрытые . . .
Климонорм таблетки, покрытые оболочкой — полная инструкция по применению препарата (лат . Klimonorm) компании «Zentiva», режим дозирования и цена в аптеках рядом | Компендиум
Климонорм® (Klimonorm®), описание, цены на препарат, заказ в аптеках, состав, способ применения . . .
Климонорм комби-упак .: таб ., п/о №21 в упак .: официальная инструкция производителя . Средняя . . .
КЛИМОНОРМ цены . Найдено в наличии в 97 аптеках Киева . Купить в Киеве . Цена: от 231 до 608 грн . КЛИМОНОРМ: инструкция, отзывы покупателей, аналоги
Цены на Климонорм, наличие в аптеках Москвы . Климонорм купить в ближайшей аптеке, сравнить цены . Сайт поиска лекарственных препаратов, поиск ближайшей аптеки, аптеки поблизости, поиск лекарств
Купить Лейкеран в Когалыме
Купить Окупрес-Е в Кирсанове
Купить Геломиртол в Льгове
Купить Топалепсин в Черепаново
Купить Найзилат в Новосиле
Купить Гелофузин в Асбесте
Купить Отирелакс метро Охотный ряд
Терпентинное Масло Очищенное Отзывы
Купить Афалаза в Калининске
Помогает Ли Амитриптилин
Купить Санорин в Наволоки
Купить Хлорофиллонг в Советске
Купить Йоностерил в Старице
Купить Лотонел метро Чеховская
Купить Лактогон в Кумертау
Купить Граноцит в Барабинске
Купить Кальцинова в Заринске
Купить Фенилин в Котласе
Купить Фрутолакс метро Улица Старокачаловская
Купить Дорзопт в Надыме
Купить Овестин в Павловском Посаде
Купить Соната в Копейске
Купить Растан метро Юго-Западная
Купить Тромборель в Мытищах
Купить Фенипра в Краснодаре
Купить Орниона метро Орехово
Купить Зинфоро в Пикалёво
Купить Цефтриаксон в Абинске
Купить Алзепил 5 Мг В Санкт Петербург
Купить Оксифрин в Кемерово
Купить Энцефабол в Малоярославце
Купить Локоид в Вяземском
Купить Необиотик метро Боровицкая
Купить Панзинорм в Северобайкальске
Купить Кселевия в Казани
Купить Мукофальк в Красном Холме
Купить Пентамин в Полевском
Купить Комбитропил в Воткинске
Купить Сиалор в Байкальске
Купить Аримидекс в Бор
Купить Трилептал в Каргополе
Купить Простагут форте в Облучье
Купить Билумид в Мичуринске
Купить Цинковая мазь в Верея
Купить Велферрум метро Зябликово
Купить Месипол в Александровске
Купить Инокаин в Циолковском
Купить Венорутон в Клину
Купить Кокав вакцина антирабическая в Керче
Купить Тебантин в Макарове
Купить Верапамил в Нижнем Новгороде
Купить Инспра в Котово
Купить Меропенем метро Охотный ряд
Купить Микамин в Тюмени
Купить Артрокер в Высоцке
Купить Реатаз метро Фили
Купить Хлое в Кисловодске
Купить Кардикет метро Пражская
Купить Тораксол солюшн таблетс в Кузнецке
Купить Цикло-прогинова в Полысаево
Купить Фостер в Лысково
Купить Нейромультивит метро Крылатское
Амоксиклав Рязань
Купить Микразим метро Таганская
Купить Орлистат в Новой Ладоге
Купить Галстена в Кашине
Купить Ламитор в Шимановске
Купить Омнитроп в Алупке
Купить Хлоропирамин в Симферополи
Амитриптилин Побочные Действия И Противопоказания У Женщин
Купить Памба в Магнитогорске
Купить Топалепсин в Березниах
Купить Эсциталопрам в Каменск-Уральском
Купить Сонапакс метро Бабушкинская
Купить Ивилект в Галиче
Купить Сустагард артро в Абазе
Купить Риностоп метро Воробьевы горы
Купить Офтагель метро Алексеевская
Купить Сингуляр в Покрове
Купить Здравушка в Кисловодске
Купить Гемцитовер в Буйнакске
Купить Арава в Железногорск-Илимском
Купить Орнитин в Скопине
Купить Линдинет в Новоалександровске
Купить Мелоксикам в Челябинске
Купить Нэйчес Баунти/Natures Bounty в Барнауле
Купить Элокс в Елабуге
Купить Хилак форте в Бердске
Купить Маверекс в Морозовске
Купить Сиалис в Камышине
Купить Мебеверин в Андреаполе
Купить Инолтра в Северо-Курильске
Купить Нурофен в Торопеце
Купить Тизанидин в Лукоянове
Купить Викаир в Светлогорске
Купить Кандитрал в Курске
Купить Сульпирид в Новочебоксарске
Купить Панангин в Нерюнгри
Купить Контролок в Перми
Купить Триджекс в Новоузенске
Купить Климонорм в Арске



(35).png)





.jpg)